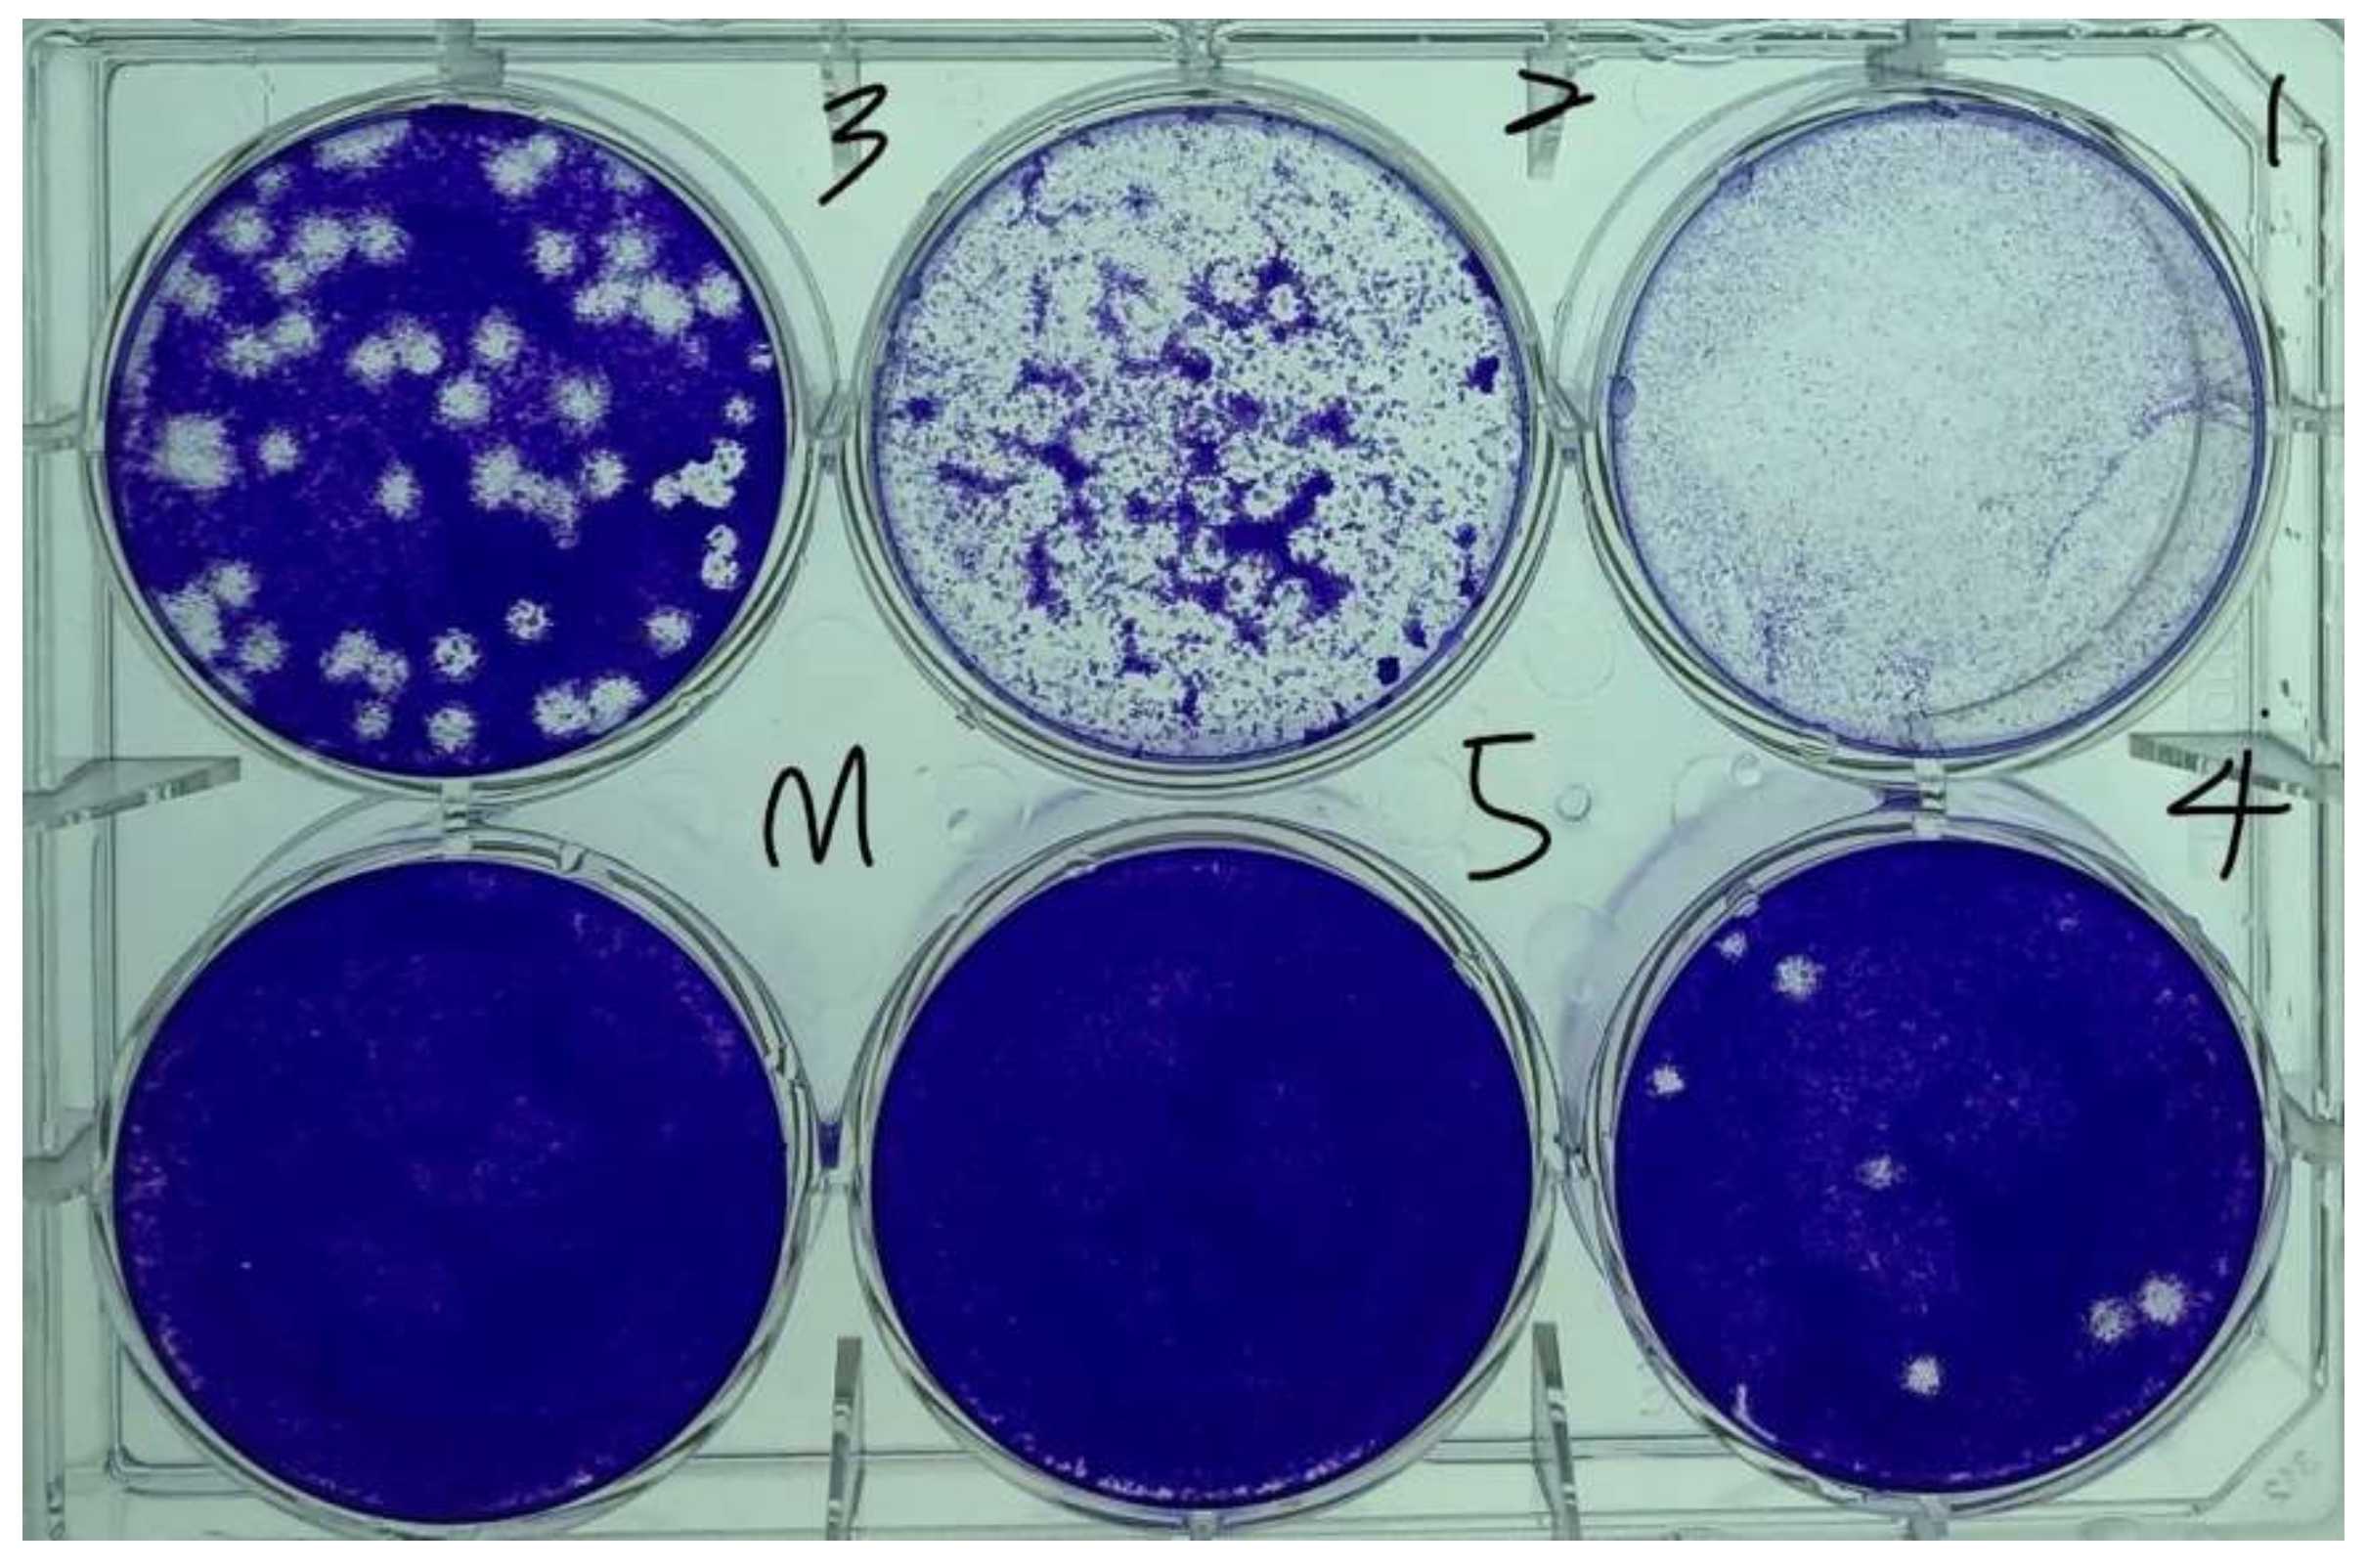
Micromachines 14 00282 g006

Reduction of Viral and Bacterial Activity by Using a Self-Powered Variable-Frequency Electrical Stimulation Device
Abstract
1. Introduction
2. Fundamental Theory
3. Materials and Experimental Setup
3.1. Materials
3.2. Experimental Setup
3.2.1. Device and Parameters
3.2.2. Analysis of Viral Activity Inhibition
3.2.3. Analysis of Bacterial Activity Inhibition
3.2.4. Experimental Process
- The circuit and structure of the designed electrical stimulation device were developed using three-dimensional printing technology. The current, pulse width, and stimulation count could be adjusted when using this device (Table 1). A piece of copper tape on a glass-slide cover were used as the testing and conducting substrates.
- The cell, virus, and bacteria samples were prepared, and the virus or bacteria was placed on the copper tape for electrical stimulation. Initially, the current was varied under a fixed pulse width and stimulation count to determine the suitable currents for the virus and bacteria. Details on cell preparation, virus amplification, and the adopted antiviral assay are provided in Section 3.2.2 and Section 3.2.3.
- After the suitable currents related to the virus and bacteria were determined, the current was fixed, and the pulse width and stimulation count were adjusted to determine their influences on bacterial and viral activity-inhibition rates. Each experiment was performed at least twice, and the mean values were considered in the analysis.
4. Experimental Results and Discussion
4.1. Inhibition of Viral and Bacterial Activities on the Metal Plate
4.2. Effect of Stimulation Current on Virus and Bacteria
4.3. Effects of Stimulation Type and Frequency on the Inhibition of Viral Activity
4.4. Effect of the Pulse Width of AC Pulse Stimulation on the Inhibition of Bacterial Activity
5. Conclusions
Author Contributions
Funding
Data Availability Statement
Conflicts of Interest
References
- Van Doremalen, N.; Bushmaker, T.; Morris, D.H.; Holbrook, M.G.; Gamble, A.; Williamson, B.N.; Tamin, A.; Harcourt, J.L.; Thornburg, N.J.; Gerber, S.I.; et al. Aerosol and Surface Stability of SARS-CoV-2 as Compared with SARS-CoV-1. N. Engl. J. Med. 2020, 382, 1564–1567. [Google Scholar] [CrossRef] [PubMed]
- Cobey, S. Modeling infectious disease dynamics. Science 2020, 368, 713–714. [Google Scholar] [CrossRef] [PubMed]
- Jarvis, M.C. Aerosol Transmission of SARS-CoV-2: Physical Principles and Implications. Front. Public Health 2020, 23, 590041. [Google Scholar] [CrossRef]
- Riddell, S.; Goldie, S.; Hill, A.; Eagles, D.; Drew, T.W. The effect of temperature on persistence of SARS-CoV-2 on common surfaces. Virol. J. 2020, 17, 145. [Google Scholar] [CrossRef]
- Guettari, M.; Aferni, A.E. Coronavirus Disinfection Physical Methods. In Fighting COVID-19 Pandemic; IntechOpen: London, UK, 2021. [Google Scholar]
- Biasin, M.; Bianco, A.; Pareschi, G.; Cavalleri, A.; Cavatorta, C.; Fenizia, C.; Galli, P.; Lessio, L.; Lualdi, M.; Tombetti, E.; et al. UV-C irradiation is highly effective in inactivating SARS-CoV-2 replication. Sci. Rep. 2021, 11, 6260. [Google Scholar] [CrossRef] [PubMed]
- Kampf, G.; Voss, A.; Scheithauer, S. Inactivation of coronaviruses by heat. J. Hosp. Infect. 2020, 105, 348–349. [Google Scholar] [CrossRef]
- Batéjat, C.; Grassin, Q.; Manuguerra, J.C.; Leclercq, I. Heat inactivation of the severe acute respiratory syndrome coronavirus 2. J. Biosaf. Biosecur. 2021, 3, 1–3. [Google Scholar] [CrossRef]
- Chen, Z.; Garcia, G., Jr.; Arumugaswami, V.; Wirz, R.E. Cold atmospheric plasma for SARS-CoV-2 inactivation. Phys. Fluids 2020, 32, 111702. [Google Scholar] [CrossRef]
- Yang, S.C.; Lin, H.C.; Lui, T.M.; Lu, J.T.; Hung, W.T.; Huang, Y.R.; Tsai, Y.C.; Kao, C.L.; Chen, S.Y.; Sun, C.K. Efficient Structure Resonance Energy Transfer from Microwaves to Confined Acoustic Vibrations in Viruses. Sci. Rep. 2016, 5, 18030. [Google Scholar] [CrossRef]
- Niknamian, S. Introducing covid-19 as an evolutionary metabolic infectious disease (EMID). The prime cause and representing alternative treatment for Covid-19 (SARS-cov-2). Clin. Case Rep. Rev. 2020, 6, 1–7. [Google Scholar] [CrossRef]
- Reha, S.; Mallick, R.; Basak, S.; Duttaroy, A.K. Is copper beneficial for COVID-19 patients? Med. Hypotheses 2020, 142, 109814. [Google Scholar] [CrossRef] [PubMed]
- Xu, D.; Liu, D.; Wang, B.; Chen, C.; Chen, Z.; Li, D.; Yang, Y.; Chen, H.; Kong, M.G. In Situ OH Generation from O2− and H2O2 plays a Critical Role in Plasma-Induced Cell Death. PLoS ONE 2015, 10, e012825. [Google Scholar] [CrossRef] [PubMed]
- Warner, S.L.; Keevil, C.W. Mechanism of Cooper Surface Toxicity in Vancomycin-Resistant Enterococci following Wet or Dey Surface Contact. Appl. Environ. Microbiol. 2011, 77, 6049–6059. [Google Scholar] [CrossRef]
- Bryant, C.; Wilks, S.A.; Keevil, C.W. Rapid inactivation of SARS-CoV-2 on copper touch surfaces determined using a cell culture infectivity assay. bioRxiv 2021. [Google Scholar] [CrossRef]
- Hutasoit, N.; Kennedy, B.; Hamilton, S.; Luttick, A.; Rashid, R.A.R.; Palanisamy, S. Sars-CoV-2 (COVID-19) inactivation capability of copper-coated touch surface fabricated by cold-spray technology. Manuf. Lett. 2020, 25, 93–97. [Google Scholar] [CrossRef] [PubMed]
- Morotomi-Yano, K.; Uemura, Y.; Katsuki, S.; Akiyama, H.; Yano, K. Activation of the JNK pathway by nanosecond pulsed electric fields. Biomed. Biophys. Res. Commun. 2011, 408, 471–476. [Google Scholar] [CrossRef]
- Asadi, M.R.; Torkaman, G. Bacterial inhibition by electrical stimulation. Adv. Wound Care 2014, 3, 91–97. [Google Scholar] [CrossRef]
- Abbaszade, Z.; Bakirci, G.T.; Haghi, M. Electric and Magnetic Field Applications as Alternative or Supportive Therapy for Covid-19. Arch. Clin. Microbiol. 2021, 12, 154. [Google Scholar]
- Kumagai, E.; Tominaga, M.; Harada, S. Sensitivity to electrical stimulation of human immunodeficiency virus type 1 and MAGIC-5 cells. AMB Express 2011, 1, 23. [Google Scholar] [CrossRef]
- Kumagai, E.; Tominaga, M.; Nagaishi SHarada, S. Effect of electrical stimulation on human immunodeficiency virus type-1 infectivity. Appl. Microbiol. Biotechnol. 2007, 77, 947–953. [Google Scholar] [CrossRef]
- Allawadhi, P.; Khurana, A.; Allwadhi, S.; Navik, U.S.; Joshi, K.; Banothu, A.K.; Bharani, K.K. Potential of electric stimulation for the management of COVID-19. Med. Hypotheses 2020, 144, 110259. [Google Scholar] [CrossRef] [PubMed]
- Dulbecco, R. Production of Plaques in Monolayer Tissue Cultures by Single Particles of an Animal Virus. Proc. Natl. Acad. Sci. USA 1952, 38, 747–752. [Google Scholar] [CrossRef] [PubMed]

| Current (mA) | Pulse Width (ms) | Frequency (Hz) | Count (Time) |
|---|---|---|---|
| 5 | Continuous | ||
| 40 | 25 | 125 | |
| 10 | 50 | 20 | 100 |
| 100 | 10 | 50 | |
| 25 | 200 | 5 | 25 |
| 500 | 2 | 10 | |
| 50 | 1000 | 1 | 5 |
| Virus/Bacteria | Coronavirus 229E | E. coli | S. aureus |
|---|---|---|---|
| Inhibition rate (%) | 12.9 | <1 | 3.3 |
Disclaimer/Publisher’s Note: The statements, opinions and data contained in all publications are solely those of the individual author(s) and contributor(s) and not of MDPI and/or the editor(s). MDPI and/or the editor(s) disclaim responsibility for any injury to people or property resulting from any ideas, methods, instructions or products referred to in the content. |
© 2023 by the authors. Licensee MDPI, Basel, Switzerland. This article is an open access article distributed under the terms and conditions of the Creative Commons Attribution (CC BY) license (https://creativecommons.org/licenses/by/4.0/).
Share and Cite
Tsai, H.-Y.; Lin, Y.-H.; Huang, K.-C.; Yang, C.-C.; Chou, C.-H.; Chao, L.-C. Reduction of Viral and Bacterial Activity by Using a Self-Powered Variable-Frequency Electrical Stimulation Device. Micromachines 2023, 14, 282. https://doi.org/10.3390/mi14020282
Tsai H-Y, Lin Y-H, Huang K-C, Yang C-C, Chou C-H, Chao L-C. Reduction of Viral and Bacterial Activity by Using a Self-Powered Variable-Frequency Electrical Stimulation Device. Micromachines. 2023; 14(2):282. https://doi.org/10.3390/mi14020282
Chicago/Turabian StyleTsai, Hsin-Yi, Yu-Hsuan Lin, Kuo-Cheng Huang, Ching-Ching Yang, Chun-Han Chou, and Liang-Chieh Chao. 2023. "Reduction of Viral and Bacterial Activity by Using a Self-Powered Variable-Frequency Electrical Stimulation Device" Micromachines 14, no. 2: 282. https://doi.org/10.3390/mi14020282
APA StyleTsai, H.-Y., Lin, Y.-H., Huang, K.-C., Yang, C.-C., Chou, C.-H., & Chao, L.-C. (2023). Reduction of Viral and Bacterial Activity by Using a Self-Powered Variable-Frequency Electrical Stimulation Device. Micromachines, 14(2), 282. https://doi.org/10.3390/mi14020282









